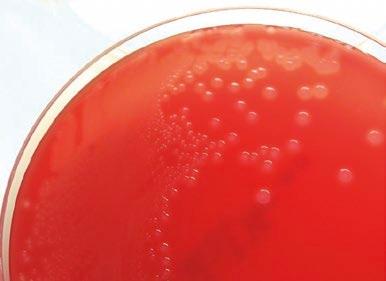

6 minute read
ESTUDIO DE SENSIBILIDAD ANTIBIÓTICA EN PROCESOS RESPIRATORIOS EN GANADO BOVINO
El Síndrome Respiratorio Bovino suele estar ocasionado por coinfecciones de diferentes agentes:

BACTERIANOS
Pasteurella multocida
Mannheimia haemolytica
Histophilus somni
Mycoplasmopsis bovis
El tratamiento de estos procesos suele ser y, en el caso de las antibiótico
RESISTENCIAS ANTIMICROBIANAS - aumento de las resistencias a los antibióticos y por la carencia de desarrollo de nuevas moléculas, uno de los mayores para preservar su efectividad en animales y personas, además de intentar reducir la propagación de las resistencias antimicrobianas entre las distintas especies y en el medioambiente.
Para poder desempeñar una mejor labor clínica y contribuir a estas medidas de control, una de las herramientas más accesibles para estudio de la en cada caso, que le ayude a elegir el tratamiento más idóneo.
VÍRICOS
Virus Respiratorio Sincitial Bovino
Coronavirus Bovino
Parainfluenza 3
Virus de la Rinotraqueítis
Infecciosa Bovina
Virus de la Diarrea Vírica
Bovina
También es de utilidad contar con un histórico de resultados para poder valorar la evolución de la sensibilidad antibiótica con el tiempo y así poder detectar, por ejemplo, si un tratamiento está perdiendo efectividad.
PRUEBAS DE SENSIBILIDAD PARA AFRONTAR LAS RESISTENCIAS ANTIMICROBIANAS
En este artículo, se mostrarán resultados de sensibilidad antibiótica de Pasteurella multocida, Mannheimia haemolytica e Histophilus somni, recopilados de casos clínicos que cursaban con un proceso respiratorio.
Este tipo de ensayos, también denominados antibiogramas, consisten en testar la sensibilidad antibiótica in vitro con el propósito de correlacionar estos resultados con la práctica clínica.
Contamos con distintas técnicas para llevarlo a cabo, pero una de las más comunes es la de Kirby-Bauer o método con discos en difusión en agar.
Toma de muestras
Para poder obtener un resultado fiable, uno de los aspectos más importantes es realizar una correcta toma de muestras.
Es necesario seleccionar correctamente a los animales para realizar el muestreo y asegurarse de que, hasta que la muestra llegue al laboratorio, se ha conservado de una manera apropiada.
Algunas de las medidas para garantizar esto son:
Seleccionar varios animales que sean representativos de la población con sintomatología respiratoria y que no hayan sido tratados con antibióticos previamente.
Si es posible, evitar tomar muestras de animales crónicos.
Enviar muestras de animales muertos recientemente para evitar la autolisis y contaminación de los órganos.
Si se envían órganos, hay que separarlos en distintos recipientes herméticos.
Conservar las muestras refrigeradas, sobre todo durante el envío, e intentar que lleguen al laboratorio como máximo en 24 horas.
Aislamiento bacteriano
En las Imágenes 1, 2 y 3 se pueden observar aislamientos de las bacterias Pasteurella multocida, Mannheimia haemolytica e Histophilus somni.
1 2 posteriormente, se procede al aislamiento bacteriano en un cultivo puro que servirá para identificar qué bacteria es la causante de la infección y para realizar el estudio de sensibilidad antibiótica.
Tras la recepción de la muestra en el laboratorio, se siembra en los medios de cultivo adecuados en función del tipo de muestra y de las bacterias que se sospecha que puedan estar implicadas.

Prueba de sensibilidad antibiótica: Kirby-Bauer
Con el fin de evaluar la sensibilidad antibiótica de colonias obtenidas durante el aislamiento 3
4 5
Una vez preparada, la placa se incuba en las condiciones correspondientes para la bacteria, normalmente durante 18-24 horas a 37 0C.
Las condiciones de cultivo están establecidas por organismos oficiales como: Clinical & Laboratory Standards Institute (CLSI) y European Committee on Antimicrobial Susceptibility Testing (EUCAST), y se deben seguir rigurosamente para obtener resultados fiables además de comparables entre laboratorios.
Tras la incubación de la placa, alrededor del disco se obtiene un halo de inhibición del crecimiento bacteriano (Imagen 5), del cual medimos el diámetro (mm) (Figura 1)


La medida del diámetro de halo obtenido se compara con los puntos de corte clínicos para valorar la sensibilidad. Estos puntos de corte se obtienen del CLSI, del EUCAST y/o de estudios científicos publicados y vienen determinados en función de:
El antibiótico
La especie animal
La especie bacteriana
El proceso patológico
Imagen 5. Antibiograma mediante la técnica de Kirby-Bauer. En la imagen se pueden observar los halos de inhibición alrededor de los 4 discos de la parte superior y la ausencia en los dos discos de la parte inferior.
En función de los puntos de corte, se podrá clasificar la bacteria como: Sensible
Sensibilidad intermedia Resistente
Figura 1. Medición de los halos de inhibición de crecimiento bacteriano para clasificar la bacteria en sensible, de sensibilidad intermedia o resistente frente a cada uno de los antibióticos testados (creado con BioRender.com).

Esta clasificación indica la probabilidad de éxito terapéutico de cada uno de los antibióticos analizados, siempre siguiendo las indicaciones de dosificación y pauta posológica de las fichas técnicas.
Disco impregnado de antibiótico
Zona de inhibición de crecimiento bacteriano
Crecimiento bacteriano
Resultados De Sensibilidad Antibi Tica De Procesos Respiratorios
Se han recopilado los resultados obtenidos en Exopol desde 2019 hasta 2022 del estudio de sensibilidad antibiótica con la técnica de antibiograma en disco, Kirby-Bauer, de las cepas bacterianas Mannheimia haemolytica, Pasteurella multocida e Histophilus somni procedentes de muestras respiratorias de bovino de casos clínicos de la Península Ibérica.
En las Gráficas 1, 2 y 3 se puede ver, por año estudiado, el porcentaje de cepas de cada bacteria que fueron sensibles a cada uno de los antibióticos analizados.
Mannheimia haemolytica y Pasteurella multocida
Los resultados del porcentaje de cepas sensibles de Mannheimia haemolytica y de Pasteurella multocida son muy similares para todos los antibióticos analizados. De estas dos bacterias en los últimos años se observan menos de un 50% de cepas sensibles a:
Tetraciclina
Tianfenicol
Gamitromicina
Tulatromicina
Tilmicosina
Estreptomicina
Eritromicina
Flumequina
Doxiciclina
Mannheimia haemolytica
En el caso de Mannheimia haemolytica se ha encontrado una disminución estadísticamente significativa de la sensibilidad con el tiempo para la tetraciclina y la eritromicina.
Esto demuestra que cada año aumenta el número de cepas resistentes a estos antibióticos y que es necesario tomar medidas para frenarlo.
Todos ellos están indicados para el tratamiento de estas infecciones y la mayoría son de uso habitual en la práctica clínica, así que esta pérdida de efectividad puede estar ocasionada por su uso frecuente.
Gráfica 1. Resultados de sensibilidad antibiótica de Mannheimia haemolytica. Se ha evaluado la evolución de la sensibilidad de cada antibiótico a lo largo del tiempo mediante la prueba estadística Chi-cuadrado. Se ha considerado que las variables tiempo y sensibilidad son dependientes, es decir, que existen diferencias significativas entre porcentaje de sensibles de los diferentes periodos de tiempo, si p-valor < 0,01(*). No hay datos de tulatromicina de los años: 2019, 2020 y 2021; de cefquinoma, flumequina y doxiciclina de los años: 2019 y 2020; y de marbofloxacino del año 2019.
Resultados de sensiblidad antibiótica de Pasteurella multocida
2019 (N= 116)
2020 (N= 83)
2021 (N= 139) 2022 (N= 130)
Gráfica 2. Resultados de sensibilidad antibiótica de Pasteurella multocida. Se ha evaluado la evolución de la sensibilidad de cada antibiótico a lo largo del tiempo mediante la prueba estadística Chi-cuadrado. Se ha considerado que las variables tiempo y sensibilidad son dependientes, es decir que existen diferencias significativas entre porcentaje de sensibles de los diferentes periodos de tiempo, si p-valor < 0,01(*). No hay datos de tulatromicina de los años: 2019, 2020 y 2021; de cefquinoma, flumequina y doxiciclina de los años: 2019 y 2020; y de marbofloxacino del año 2019.
Histophilus somni
Para Histophilus somni hay algunas diferencias respecto a las otras dos bacterias, aunque pueden deberse al menor número de muestras analizadas.
En este caso, al menos en los 2 últimos años se observan menos de un 50% de cepas sensibles a:
En cambio, hay antibióticos que presentan un alto porcentaje de cepas sensibles a ellos como:
Trimetoprima-sulfametoxazol
Amoxicilina
Cefquinoma
Ceftiofur
Tetraciclina
Gentamicina
Tianfenicol
Tulatromicina
Tilmicosina
Eritromicina
Doxiciclina
De hecho, se ha observado una disminución estadísticamente significativa de la sensibilidad con el tiempo de la tilmicosina.
Gráfica 3. Resultados de sensibilidad antibiótica de Histophilus somni. Se ha evaluado la evolución de la sensibilidad de cada antibiótico a lo largo del tiempo mediante la prueba estadística Chi-cuadrado. Se ha considerado que las variables tiempo y sensibilidad son dependientes, es decir que existen diferencias significativas entre porcentaje de sensibles de los diferentes periodos de tiempo, si p-valor < 0,01(*). No hay datos de tulatromicina de los años: 2019, 2020 y 2021; de cefquinoma, flumequina y doxiciclina de los años: 2019 y 2020; y de marbofloxacino del año 2019.
Conclusiones
Las pruebas de sensibilidad antibiótica son un aliado del veterinario, ya que ayudan a instaurar los tratamientos más idóneos en cada situación y permiten valorar la evolución de la sensibilidad antibiótica en la explotación.
Para el tratamiento de las infecciones respiratorias hay un gran número de antibióticos registrados con esta indicación para ganado bovino, así que, en la medida de lo posible, hay que elegir la opción de tratamiento que más probabilidades de éxito tenga basándose en los resultados de sensibilidad antibiótica.
En general, las bacterias estudiadas en este artículo suelen ser cepas sensibles a la mayoría de los antibióticos, sobre todo Histophilus somni
No obstante, hay que prestar especial atención a las moléculas que van perdiendo efectividad con los años, como tetraciclina, eritromicina, tilmicosina y marbofloxacino, o que presentan menos de un 20% de cepas sensibles a ellos, como en el caso de Mannheimia haemolytica y Pasteurella multocida con eritromicina y doxiciclina.
Es necesario seguir recopilando resultados de sensibilidad antibiótica e ir evaluando si la situación en las granjas de la Península Ibérica se mantiene estable o si se observa un cambio significativo de la sensibilidad con el tiempo. De este modo, se podrán tomar medidas con antelación que frenen la difusión de las resistencias antibióticas.
Estudio de sensibilidad antibiótica en procesos respiratorios en ganado bovino DESCÁRGALO EN PDF